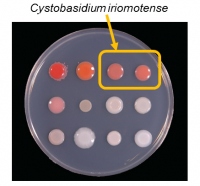
グルコースとキシロースを効率的に取り込み油脂を生産する酵母。（画像:理化学研究所発表資料より）

本田技研工業(ホンダ)は、新型のハイブリッドカー「INSIGHT(インサイト)」の2018年冬の日本発売に向け、各種情報をホームページ上で公開した。
10/05 19:44
一般公開(10月4日~10日)が始まったパリ・モーターショーで、Ferrari 488 Pista Spiderがデビューを飾った。
10/05 09:09
京都大学の矢代敏久農学研究科特定研究員(現・シドニー大学研究員)、松浦健二同教授、小林和也フィールド科学教育研究センター講師らの研究グループは、日本固有種のナカジマシロアリというシロアリが、一般的にはオスとメスが混在して暮らすシロアリの中にあって、メスのみしか存在せず単為生殖で繁殖しているという事実を明らかにした。
10/04 21:38
ハワイアンテイストのグルメバーガー&サンドウィッチレストラン「クア・アイナ」は3日より、期間限定メニューとして毎年定番の「テリヤキバーガー」が登場する。
10/03 10:54
サントリー食品インターナショナルは、セブン-イレブンを運営するセブン&アイ・ホールディングスとの共同開発により、ダブルブランドの缶コーヒー『セブンプレミアム×サントリーBOSS「セブンズボス オリジナル」』『セブンプレミアム×サントリーBOSS「セブンズボス 微糖」』、同じくダブルブランドのボトル缶コーヒー『セブンプレミアム×サントリーBOSS「セブンズボス ブラック」』を、10月16日に全国のセブンイレブン店舗で発売すると発表した。
10/03 08:49
約2万1,000年前の最後の氷河期(最終氷期最寒冷期)において、日本列島の常緑広葉樹の代表的な存在であるシイのなかまスダジイが、どうやって生き延びたかという問題について、大阪大学などの研究グループが発表を行った。
10/02 11:51
サントリー食品インターナショナルは、「クラフトボス ラテ ホット」、「クラフトボス ブラウン ホット」を10月2日から全国で発売すると発表した。
10/02 11:19
三菱トラック・バスは、小型トラック・キャンターの2018.5年モデルを、8月21日から全国三菱ふそう販売会社および三菱ふそう地域販売部門において販売開始した。
09/28 17:36
人気レーシングゲーム「マリオカート」シリーズで知られる任天堂が、東京都品川区の公道カートレンタルサービス企業マリカー(現商号はMARIモビリティ開発)を、知的財産権の侵害行為の差し止め、並びに損害賠償などで告訴していた訴訟において、任天堂が東京地裁において事実上の勝利判決を勝ち取った、
いわゆる「マリカー」であるが、ご覧になったことはおありだろうか。
09/28 08:17
2018年6月に、日本マクドナルドとしては史上初めての新テイストマックナゲットとして販売され好評を博した「スパイシーチキンマックナゲット」が、10月1日から期間限定で復活販売されることになった。
09/26 21:58
アメリカのドーナツチェーン「DUNKIN' DONUTS(ダンキンドーナツ)」は25日(現地時間)、ブランド名を「DUNKIN'(ダンキン)」に変更すると発表した。
09/26 17:36
兵庫県西宮市西宮駅直結の商業施設「エビスタ西宮」は、2017年の夏から増床などの工事を行っていたが、10月29日をもってリニューアルオープンすると発表された。
09/26 08:53
広島大学と奈良先端科学技術大学院大学の共同研究グループは、脳画像、血中バイオマーカーなどのデータを人工知能(AI)によって総合的に分析することで、うつ病の治療薬である抗うつ薬の奏功しない患者を割り出すことができるという事実を発見した。
09/24 11:22
理化学研究所(理研)バイオリソース研究センター微生物材料開発室事業推進ユニットの高島昌子ユニットリーダー、大熊盛也室長、明治薬科大学微生物学研究室の杉田隆教授、龍谷大学農学部の島純教授、京都大学大学院農学研究科の谷村あゆみ特定研究員らの共同研究グループが、バイオマス由来の2種類の糖から効率よく油脂を生産する、新種の酵母を発見した。
09/24 11:15
神戸大学大学院理学研究科の末次健司特命講師、千葉県農林総合研究センターの福島成樹森林研究所所長と森林総合研究所九州支所の末吉昌宏主任研究員らの研究グループは、多くが絶滅危惧種である植物のランの仲間の趣旨を、ランミモグリバエという種類のハエが深刻に食害している事実を明らかにした。
09/24 08:21
日本コカ・コーラは、脂肪の吸収を抑え糖の吸収を穏やかにするふたつの働きから「Wトクホ」の指定を受けた特定保健用食品の緑茶、「綾鷹 特選茶」を9月24日から発売する。
09/23 12:40
ジャガー・ランドローバー・ジャパンは、ラグジュアリ・サルーン「XJ」2019年モデルの受注を、9月21日から開始した。
09/23 08:09
日立ソリューションズ社は、紙の書類からAIが必要なデータを自動抽出してくれるクラウドサービス、「活文 Intelligent Data Extractor サービス」を10月1日から販売開始すると発表した。
09/21 11:55